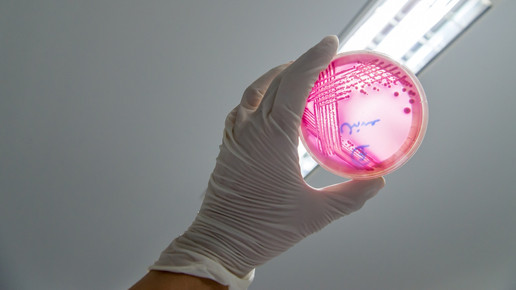
Foto: Eine Person hält eine Agarplatte mit Enterohemorrhagic Escherichia coli hoch.

Ehec: Bayern übertrifft Jahreswert schon im August
Ehec-Bakterien können schwere Erkrankungen verursachen. Aktuell gibt es Fälle in Mecklenburg-Vorpommern und in Seniorenheimen in Belgien – und auch in Bayern sind die Zahlen aktuell höher.
In Bayern sind in diesem Jahr schon mehr Ehec-Infektionen registriert worden als im kompletten Jahr 2024. Das geht aus Zahlen des Gesundheitsministeriums in München hervor. Demnach wurden bis Mitte August schon 365 Fälle gezählt. Im Vorjahr waren es in den gesamten zwölf Monaten 352.
Seit 2020 steigt die Zahl der registrierten Fälle in Bayern kontinuierlich, wie das Gesundheitsministerium mitteilte. Damals waren es 186. Im Jahr danach wurden 208 Fälle registriert, 2022 waren es 214 und 2023 schon 248.
Die Ehec-Inzidenz, also die Zahl der gemeldeten Fälle pro 100.000 Einwohner in Bayern, stieg von 1,42 im Jahr 2020 auf 2,75 in den ersten knapp acht Monaten dieses Jahres.
Keine Hinweise auf Häufung
Derzeit häufen sich Ehec-Fälle in Mecklenburg-Vorpommern, außerdem gibt es Ausbrüche in Seniorenheimen in Belgien. Die Häufung weckt Erinnerungen an einen Ausbruch in Deutschland im Jahr 2011, bei dem rund 3800 Erkrankungen erfasst wurden und mehr als 50 Menschen starben. Aktuell sieht das Robert Koch-Institut (RKI) keine Hinweise auf eine Häufung von Ehec-Fällen auch in anderen Regionen Deutschlands. Die Situation werde aber weiter sehr genau beobachtet.
Nach Angaben des Landesamts für Gesundheit und Soziales in Mecklenburg-Vorpommern ist derzeit eine Person aus Bayern betroffen.
Insbesondere Kinder gefährdet
Ehec steht für enterohämorrhagische Escherichia coli und bezeichnet bestimmte krankmachende Stämme des Darm-Bakteriums, die vor allem bei Wiederkäuern wie Rindern vorkommen. Die Erreger können über tierische Lebensmittel wie unzureichend erhitztes Fleisch oder Rohmilch, aber auch über verunreinigtes Gemüse und Trinkwasser auf den Menschen übertragen werden.
Sie bilden starke Zellgifte, die Schleimhautzellen im Darm angreifen und schwere blutige Durchfallerkrankungen auslösen können. Gefürchtet ist vor allem das hämolytisch-urämische Syndrom (HUS), eine Komplikation, die mit Blutarmut und Nierenversagen einhergehen kann. Besonders Kinder sind gefährdet, weil ihr Immunsystem und ihre Organe noch nicht vollständig ausgereift sind.
Ehec-Infektionen treten regelmäßig auf. Nach Daten des RKI wurden 2023 bundesweit mehr als 3440 Erkrankungen erfasst, 2024 rund 4570 und bis zum 27. Oktober dieses Jahres etwa 3660.

APOTHEKE ADHOC Debatte